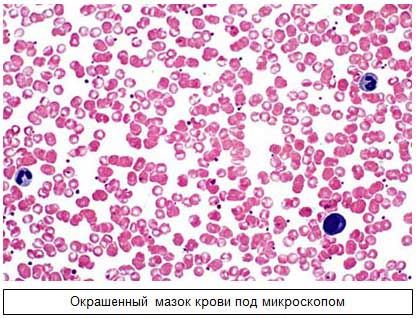
окрашенный мазок крови

Суть метода Фонио, алгоритм анализа
Многие люди не осознают, что собой представляет подсчет тромбоцитов по данному методу. Подсчет тромбоцитов по Фонио выполняется на основе анализа одной тысячи эритроцитов в мазках крови, окрашенных специальным красителем. После этого полученное число пересчитывается в соотношении на 1 литр или 1 мкл.
Этот метод обеспечивает высокую точность определения количества тромбоцитов, что, в свою очередь, способствует улучшению точности диагностики.
Врачи отмечают, что подсчет тромбоцитов по методу Фонио является важным инструментом в клинической практике. Этот метод позволяет получить более точные результаты по сравнению с традиционными подходами, что особенно актуально при диагностике различных заболеваний крови. Специалисты подчеркивают, что использование метода Фонио помогает выявить тромбоцитопению и тромбоцитоз, что может существенно повлиять на выбор дальнейшей тактики лечения.
Кроме того, врачи указывают на простоту и доступность метода, что делает его привлекательным для использования в лабораториях. Однако они также предупреждают о необходимости квалифицированной интерпретации полученных данных, так как ошибки в анализе могут привести к неправильной диагностике. В целом, метод Фонио заслуживает внимания и может стать стандартом в рутинной практике подсчета тромбоцитов.
https://youtube.com/watch?v=90rrd8B9IEU
Как делается анализ
Общее количество тромбоцитов в определенном объеме крови называется коагулограммой. Для анализа кровь берется из пальца. Этот тест необходимо пройти каждому пациенту, так как результаты могут помочь врачу выявить множество серьезных заболеваний.
При сдаче крови на тромбоциты следует учитывать несколько важных моментов:
- Уровень тромбоцитов достигает максимума после физических нагрузок и приема пищи. Поэтому анализ рекомендуется проводить не ранее чем через восемь часов после последнего приема пищи.
- То же самое касается и физической активности: если анализ выполняется в состоянии возбуждения или пациент недавно занимался тяжелой физической работой, результаты могут оказаться недостоверными.
- Кровь следует сдавать утром.
- Для повышения точности результатов рекомендуется повторить анализ еще дважды с интервалом в 3–5 дней.
| Микроскопическое поле | Количество тромбоцитов | Расчетное количество тромбоцитов в 1 мкл крови |
|---|---|---|
| 1 | 15 | (15/1) * 1500 = 22500 |
| 2 | 20 | (20/1) * 1500 = 30000 |
| 3 | 18 | (18/1) * 1500 = 27000 |
| 4 | 12 | (12/1) * 1500 = 18000 |
| 5 | 17 | (17/1) * 1500 = 25500 |
| Среднее арифметическое | 16.4 | 24600 |
Как считаются результаты
Для выполнения подсчета по методу Фонио потребуется 14%-й раствор сульфата магния и 2,6%-й раствор натрия этилендиаминтетраацетата. Реактивы следует отбирать с помощью капилляра Панченкова.
- В пробирку помещается один из реактивов, заполняя капилляр до отметки «75». Затем добавляется кровь, взятая тем же сосудом, до уровня «К».
- Компоненты необходимо тщательно смешать и подготовить тонкие мазки.
- Мазки окрашиваются по методу Романовского-Гимзе: если использовался сульфат магния, процесс окрашивания занимает два-три часа, а если ЭДТА — 35–45 минут. В этот период окрашиваются тромбоциты, которые приобретают фиолетово-розовый цвет.
Как производится подсчет тромбоцитов? В поле зрения микроскопа осуществляется подсчет эритроцитов и тромбоцитов до 1000 красных кровяных клеток. Чтобы узнать количество тромбоцитов в крови, нужно умножить их число в мазке на количество эритроцитов в 1 мкл и разделить результат на 1000. Специфическая окраска клеток позволяет врачу более точно определить количество анализируемых клеток.
Анализ крови по методу Фонио отличается высокой точностью, поэтому многие специалисты предпочитают использовать данные, полученные с помощью этой методики.
Подсчет тромбоцитов по методу Фонио вызывает разнообразные мнения среди медицинских специалистов и пациентов. Многие врачи отмечают, что этот метод позволяет получить более точные результаты по сравнению с традиционными способами, так как он минимизирует влияние различных факторов, таких как агрегация тромбоцитов. Пациенты, в свою очередь, ценят его за простоту и быстроту выполнения, что особенно важно в условиях экстренной медицинской помощи. Однако некоторые эксперты выражают сомнения в универсальности метода, указывая на необходимость дальнейших исследований для подтверждения его эффективности в различных клинических ситуациях. В целом, метод Фонио продолжает вызывать интерес и обсуждения в медицинском сообществе, что свидетельствует о его потенциале в диагностике и мониторинге заболеваний, связанных с нарушением гемостаза.
https://youtube.com/watch?v=81pg7ERlp_Q
Особенность метода Фонио
Данная методика на сегодняшний день является наиболее популярной. Основное отличие этого подхода от других заключается в том, что в мазке учитывается содержание форменных элементов, что делает его окрашенным.
Преимущества этой методики заключаются в следующем:
- лаборант имеет возможность четко различать все клетки в мазке;
- анализ крови можно проводить в любое время, не завися от момента забора образца;
- формула для подсчета количества клеток достаточно проста, и это количество зависит от тысячи красных кровяных клеток в микролитре.
О чем говорят низкие показатели
Снижение уровня тромбоцитов у человека указывает на наличие тромбоцитопении. Это состояние может возникать по нескольким причинам:
- под воздействием радиационного излучения;
- в результате отравления свинцом и другими токсичными веществами;
- при различных заболеваниях кровеносной системы;
- при наличии коллагенозов;
- в случае развития хронического нефрита.
У людей с пониженным количеством тромбоцитов часто наблюдаются внутренние кровотечения, синяки и гематомы, что связано с уменьшением эластичности сосудов. Также стоит отметить появление петехий — мелких точечных кровоизлияний.
https://youtube.com/watch?v=AHUkDvUE1Xw
О чем говорят повышенные показатели тромбоцитов
Увеличение уровня тромбоцитов в крови (тромбофилия) может наблюдаться в следующих ситуациях:
- прием определенных медикаментов;
- проведение хирургического вмешательства;
- удаление селезенки у пациента;
- травмы, сопровождающиеся значительной кровопотерей;
- наличие злокачественных опухолей;
- развитие железодефицитной анемии.
Повышенное содержание тромбоцитов представляет серьезную угрозу для здоровья и жизни человека. В таких случаях значительно возрастает вероятность тромбообразования. Это приводит к образованию сгустков крови внутри сосудов, что затрудняет нормальный кровоток.
Особенно рискованным является увеличение количества тромбоцитов у женщин в период беременности. Это может вызвать ряд серьезных осложнений:
- выраженный токсикоз;
- угроза прерывания беременности;
- задержка развития плода;
- варикозное расширение вен;
- тромбоз нижних конечностей;
- образование тромба в сосуде (тромбоэмболия);
- инфаркт миокарда.
При таких заболеваниях, как воспаление оболочек мозга, печени, легких, а также токсоплазмоз, также наблюдается рост уровня тромбоцитов. Это состояние часто сопровождается увеличением количества лейкоцитов.
Нормы у женщин, мужчин и детей
Нормальные значения тромбоцитов по методу Фонио составляют от 120 до 400 тысяч в одном кубическом миллиметре крови. Однако показатели могут значительно варьироваться в зависимости от различных групп населения, и такие различия считаются нормальными.
Для детей старше одного года нормальные значения тромбоцитов находятся в диапазоне от 180 до 320 тысяч на кубический миллиметр. У новорожденных эти пределы несколько шире — от 100 до 420 тысяч тромбоцитов в одном кубическом миллиметре крови.
У мужчин уровень тромбоцитов варьируется от 180 до 400 тысяч. Наивысшие показатели наблюдаются в возрасте 40 лет, после чего количество тромбоцитов постепенно уменьшается, но не опускается ниже 320 тысяч.
Что касается женщин, то нормальные значения составляют от 180 до 340 тысяч тромбоцитов. Максимальные показатели фиксируются в 16 лет. Во время менструаций уровень этих клеток может снижаться до 150 тысяч, а у подростков он может упасть даже до 75 тысяч.
Какие факторы влияют на количество тромбоцитов
На уровень тромбоцитов в крови влияют различные факторы. Например, острые инфекции в организме всегда приводят к увеличению числа этих клеток. Аналогичная ситуация наблюдается при нарушениях в системе кроветворения и онкологических заболеваниях.
Частые стрессы также оказывают влияние на количество тромбоцитов. Некоторые могут удивиться, но при кровопотерях уровень этих клеток возрастает. Это реакция организма, стремящегося компенсировать утрату крови.
Повышенное содержание тромбоцитов может наблюдаться и у людей, которые долгое время употребляют алкоголь.
Если же человек без контроля принимает лекарства, способствующие снижению уровня тромбоцитов, это может привести к значительным изменениям в его анализах. Подобные изменения также могут происходить при заболеваниях различных органов, таких как щитовидная железа или печень. Кроме того, даже незначительные травмы, например, порезы или носовые кровотечения, могут негативно сказаться на уровне тромбоцитов, снижая их количество.
Как нормализовать показатели тромбоцитов
Меры по нормализации уровня этих форменных элементов будут значительно варьироваться в зависимости от результатов анализа. Однако все усилия окажутся бесполезными, если на организм продолжают оказывать негативное влияние вредные факторы. Их необходимо устранить в первую очередь. Важно избегать как эмоциональных, так и физических перегрузок.
Таким образом, увеличить количество тромбоцитов можно следующими способами:
- Исключить из питания соленые продукты, алкоголь, морскую капусту и красный виноград.
- Включить в рацион такие продукты, как свежая рыба, печень, болгарский перец, яблоки и гречка.
- Врач может назначить необходимые препараты для повышения уровня тромбоцитов в крови. Самостоятельное применение таких средств строго запрещено!
- Избегать лекарств, которые могут вызывать тромбоцитопению как побочный эффект.
- Принимать витамины, такие как А, группы В и С.
Чтобы снизить уровень этих форменных элементов крови, в первую очередь необходимо наладить образ жизни и уменьшить количество стрессов. Следует избегать травмоопасных видов спорта.
Для снижения количества этих клеток крови рекомендуется:
- использовать препараты ацетилсалициловой кислоты в дозировках, рекомендованных врачом;
- отказаться от шиповника, бананов, манго и гранатов, так как эти продукты способствуют увеличению числа тромбоцитов;
- увеличить потребление клюквы, черники, облепихи, свеклы и других полезных продуктов;
- принимать поливитамины и магний;
- следить за суточным потреблением воды и избегать обезвоживания.
Как видно, метод подсчета тромбоцитов по Фонио отличается высокой точностью. Если анализ показывает отклонения от нормы, можно быстро и эффективно скорректировать уровень этих форменных элементов крови и предотвратить опасные последствия.
Если же не устранять нарушения, связанные с изменением количества таких клеток, это может привести к серьезным патологиям.
Вопрос-ответ
Что такое метод Фонио для подсчета тромбоцитов?
Метод Фонио — это лабораторный способ подсчета тромбоцитов, основанный на использовании специального микроскопа и окрашивания образца крови. Он позволяет точно определить количество тромбоцитов в образце, что важно для диагностики различных заболеваний и оценки состояния свертывающей системы крови.
Каковы преимущества метода Фонио по сравнению с другими методами подсчета тромбоцитов?
Преимущества метода Фонио включают высокую точность и надежность результатов, возможность выявления аномалий в морфологии тромбоцитов, а также простоту в использовании. В отличие от автоматизированных анализаторов, метод Фонио позволяет более детально изучить образец и выявить возможные патологические изменения.
Какие факторы могут повлиять на результаты подсчета тромбоцитов по методу Фонио?
На результаты подсчета тромбоцитов могут влиять различные факторы, такие как качество и свежесть образца крови, техника забора крови, а также наличие гемолиза или агрегации тромбоцитов. Кроме того, неправильная подготовка образца или ошибки в окрашивании могут привести к искажению результатов.
Советы
СОВЕТ №1
Перед началом подсчета тромбоцитов по методу Фонио, убедитесь, что все используемые инструменты и реактивы стерильны и правильно откалиброваны. Это поможет избежать ошибок в измерениях и повысит точность результатов.
СОВЕТ №2
Обратите внимание на правильную подготовку образца крови. Используйте антикоагулянты, чтобы предотвратить свертывание, и тщательно перемешайте образец перед анализом, чтобы равномерно распределить тромбоциты.
СОВЕТ №3
При подсчете тромбоцитов по методу Фонио старайтесь работать в условиях хорошего освещения и используйте увеличительное стекло или микроскоп для более точного визуального анализа. Это поможет вам избежать пропуска мелких тромбоцитов.
СОВЕТ №4
Не забывайте о необходимости повторного подсчета тромбоцитов для повышения надежности результатов. Сравните полученные данные с предыдущими анализами, чтобы выявить возможные отклонения и тенденции в состоянии пациента.